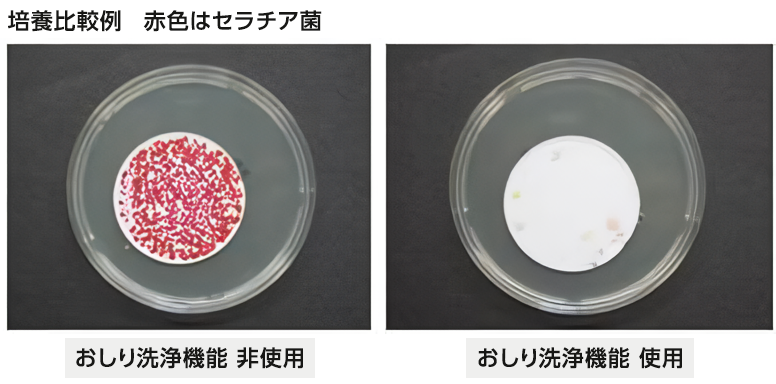
セラチア菌　培養比較例

排便後の手指衛生についての実験的検討 ― 温水洗浄便座の使用の有無による比較 ―
研究名:
排便後の手指衛生についての実験的検討 ― 温水洗浄便座の使用の有無による比較 ―
研究機関:
山口大学、宇部フロンティア大学
研究代表者 宇部フロンティア大学人間健康学部看護学科教授 尾家 重治
目的:
排便時に手指が糞便由来の微生物汚染を受けると、ノロウイルス胃腸炎等感染症の伝播に大きな影響があると推定される。しかし、排便後の手指の微生物汚染に関する報告は見当たらない。一方、近年、温水洗浄便座が急速に普及してきている。排便後の手指汚染に対する温水洗浄便座の有効性について実験的に検討した。
方法:
模擬軟便(主成分は吸水ポリマーと顔料)を作製し、この人工下痢便にセラチア菌を適量懸濁させた。その人工下痢便をお尻模型へ塗布した。その後、この汚染お尻に対して、温水洗浄便座の使用の有無の後にトイレットペーパーで拭いて、その後に手袋に付着したセラチア菌量を調べた。
結果:
手袋へのセラチア菌の付着は、温水洗浄便座非使用時で15名中15名(100%)、温水洗浄便座使用時で15名中1名(6.7%)であった。また、汚染菌量の平均値±標準偏差は、温水洗浄便座非使用時で4,275.8±6,069.7 cfu/手袋、温水洗浄便座使用時で0.067±0.249cfu/手袋であった。手袋に付着したセラチア菌量は、温水洗浄便座使用時で有意に減少した(p<0.00001)。
結論:
温水洗浄便座の使用は手袋への糞便の付着防止に極めて有効との結果が得られた。排便後には手指衛生を行うのが原則ではあるものの、十分な手洗いが行えなかった場合や、手洗いを行わなかった場合であっても、温水洗浄便座を用いていれば十分な手指衛生が保てることが推定できた。温水洗浄便座の使用は、ノロウイルス胃腸炎などの腸管感染症のみならず、多剤耐性菌の伝播防止にも有効と推定される。なお、感染リスク対策として1日1回程度の温水洗浄便座のノズル部分の用手による洗浄が推奨される。用手による機械的洗浄は、緑膿菌などのバイオフィルムの形成抑制に有効と推定される。
掲載:
学術論文はJapanese Journal of Infectious Disease 2018 Volume 71 Issue 4 306-308に掲載。
詳細はこちら(外部サイト)をご覧ください。
(全文を読むには、Download PDFボタンをクリック)
参考写真:実験の様子

出典:Shigeharu Oie, Hiromi Aoshika, Emiko Arita, Akira Kamiya. The Use ofElectric Toilet Seats with Water Spray Is Efficacious in Maintaining Hand Hygiene inExperimental Model. Japanese Journal of Infectious Disease 2018 Volume 71 Issue 406-308